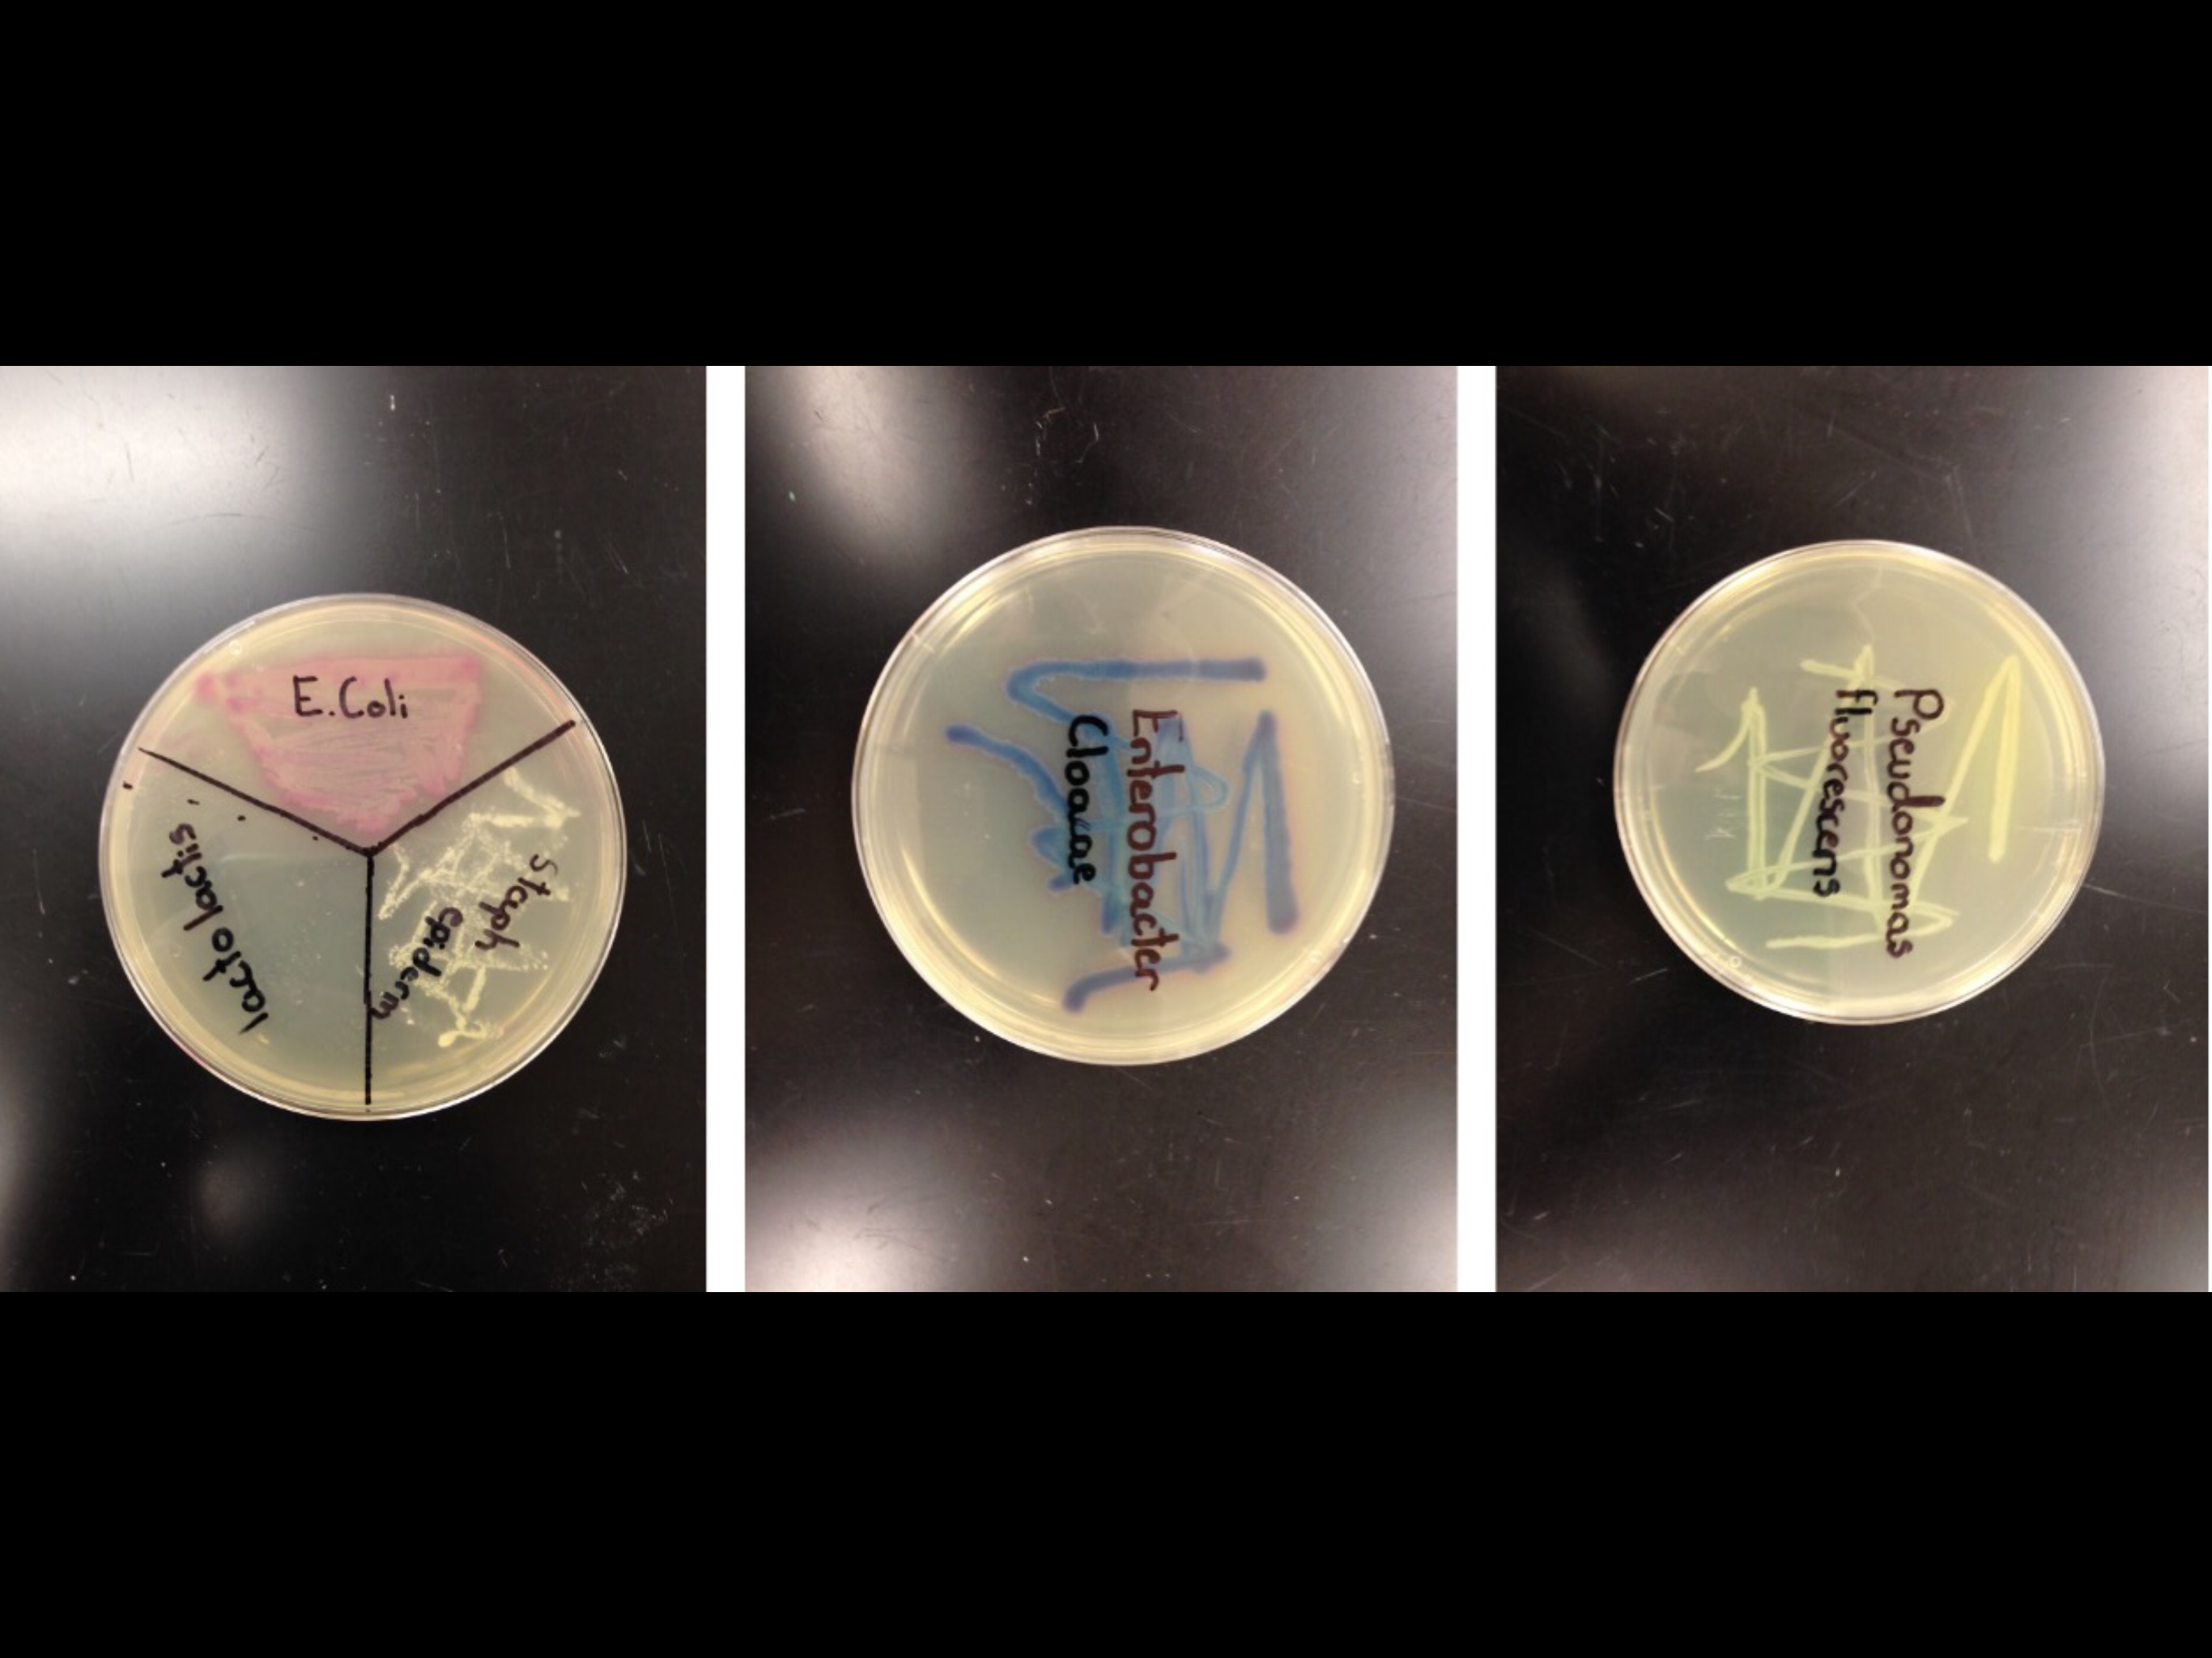
Sean Teng

Pro Angiogenic Effects of Stem Cell Therapy In Modulating Cardiovascular Functional Parameters After Chronic Kidney Disease (CKD) Induction
Pro Angiogenic Effects of Stem Cell Therapy In Modulating Cardiovascular Functional Parameters After Chronic Kidney Disease (CKD) Induction
Jordan Moldow, Pine Crest High School
Chronic Kidney Disease (CKD), characterized by a decrease in glomerular filtration rate may lead to kidney failure and heart failure with preserved ejection fraction (HFPEF). I hypothesized that Stem cells would restore kidney function due to their pro-angiogenic properties and consequently stop heart failure (HF) because of the established correlation between CKD and HF.
 The Effects of Prolonged E-Cigarette Vapor Exposure on Saccharomycese cerevisiae (Yeast) Gene Expression
The Effects of Prolonged E-Cigarette Vapor Exposure on Saccharomycese cerevisiae (Yeast) Gene Expression
Katirina Alexandra Delviscio, Pine Crest High School
Electronic cigarettes come in many different forms, but the vapor they all produce comes from an e-liquid, which is usually made up of nicotine, propylene glycol, glycerin, and flavorings. The main problem with e-cigarettes is that the long-term effects have not been documented. My research addresses this question by exposing Saccharomyces cerevisiae multiple times to e-cigarette vapor.
 Can Flavonoids Cause DNA Damage and Chromosomal Translocations Similar to Those Seen in Leukemia?
Can Flavonoids Cause DNA Damage and Chromosomal Translocations Similar to Those Seen in Leukemia?
Mimi Ughetta, The Lawrenceville School
The lab’s hypothesis was flavonoids in our environment cause translocations that lead to leukemia. It was concluded that despite being good in small doses, a high flavonoid diet including genistein and quercetin increases the risk for leukemia.
 The Effect of Lead (II) Carbonate on Gene Expression of Saccharomyces cerevisiae
The Effect of Lead (II) Carbonate on Gene Expression of Saccharomyces cerevisiae
Rodrigo Torrejon, Pine Crest High School
Lead has been proven to be a neurotoxin that affects both motor and cognitive function, as well also being linked to cancer and other complications. Several studies indicated that lead poisoning in children can cause a drop in 7 IQ points, not to mention further lethal complications. In order to further observe lead’s detrimental effects on the human body, the following research will be conducted on Saccharomyces cerevisiae, for it shares more than a third of its genome with humans.
 Alternative Splice Variant Expression of MCIDAS Does Not Induce Ciliated Cell Differentiation
Alternative Splice Variant Expression of MCIDAS Does Not Induce Ciliated Cell Differentiation
Saagar Jain, Pine Crest High School
Ciliated cell differentiation in the lung airway epithelium is necessary for the efficient removal of toxins from the airway. This research suggests that two splice variants of the MCIDAS gene do not induce ciliated cell differentiation in the lung epithelium.
Identifying Microbes with Chromogenic Media
Identifying Microbes with Chromogenic Media
Sean Teng, American Heritage High School
Finding the color change from chromogenic media to develop chromogenic library of non pathogenic bacteria, to identify contaminants, and to be able to quantify the color changes using image analysis.
 A Novel Approach to Improving Photodynamic Therapy Through Analysis of the Effects of Induced Hypoxia and Utilization of Bioluminescence
A Novel Approach to Improving Photodynamic Therapy Through Analysis of the Effects of Induced Hypoxia and Utilization of Bioluminescence
Shannen Prindle, Oakton High School
Photodynamic therapy (PDT) is a form of a cancer treatment that involves administering a photosensitizing drug and irradiating it with an external light source. Upon exposure, the photosensitizer produces a highly reactive oxygen species (ROS) which is toxic to the macromolecules within cells and results in their death. This project revolved around developing a novel approach to overcoming two major obstacles involved in PDT through the investigation of the effects of hypoxia induction and the utilization of bioluminescence.
 5-hemi-hydroxymethylcytosine in E-Box Motifs ACAT|GTG and ACAC|GTG Increases DNA-binding of the B-HLH Transcription Factor TCF4 but not USF1
5-hemi-hydroxymethylcytosine in E-Box Motifs ACAT|GTG and ACAC|GTG Increases DNA-binding of the B-HLH Transcription Factor TCF4 but not USF1
Shriyash Upadhyay, Montogomery Blair High School
To explore potential changes in sequence-specific DNA binding of transcription factors, Agilent DNA microarrays were used to conduct double stranding reactions with 5-methylcytosine (5mC) or 5-hydroxymethylcytosine (5hmC). Using this technical innovation, DNA binding specificity of two helix-loop-helix proteins, TCF4 and USF1, was explored.
 Assay Development for Biofilm Quantification and Assessment
Assay Development for Biofilm Quantification and Assessment
Thomas Weiss, Gartrell Bowling, and Hyeveen Cho, United States Military Academy
Our research offers an in vitro assay of assessing the biofilm formation of Acinetobacter baumannii. Ultimately, our project's goal is to provide useful insight for hospitals to effectively treat surfaces and decrease bacterial growth in the form of a biofilm.

Inhibition of Bone Metastasis in MDA-MB-231 and PC-3 Cells by the Extracellular Adherence Protein of Staphylococcus aureus
Trishala Kumar, American Heritage High School
This project looked at the effect of S.aureus protein A on the bone metastatic processes of breast and prostate cancer. It was found that S. aureus Protein A in all was just as, if not more, effective than the positive control, a known antimetastatic agent, at the highest concentration.